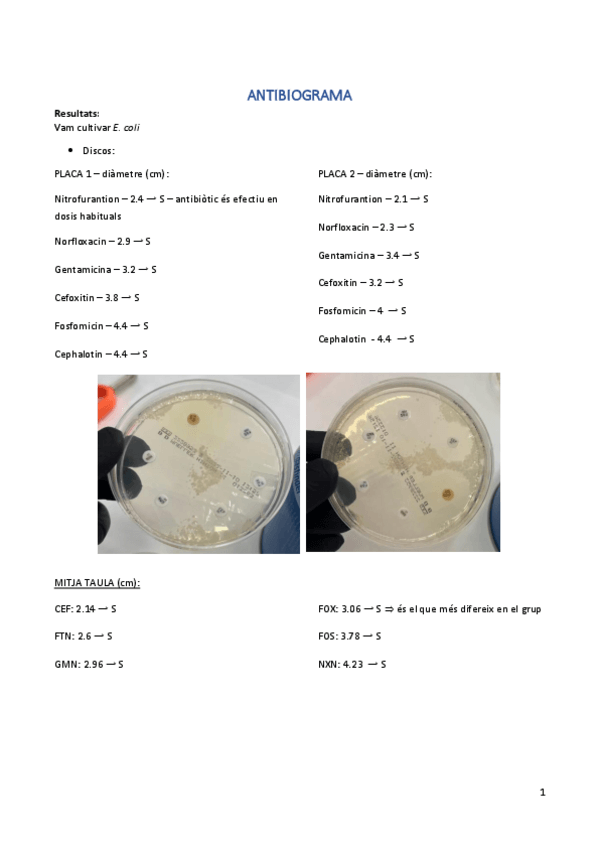
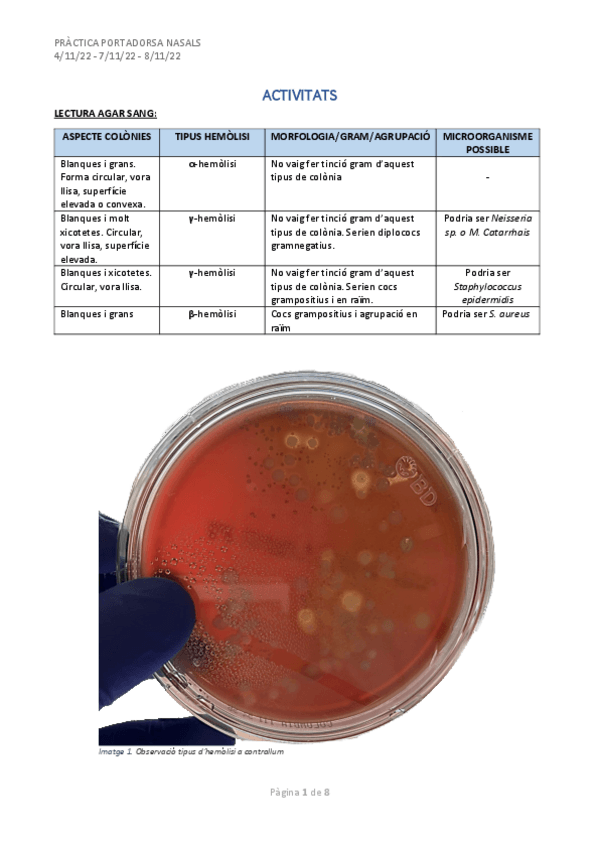

Sube tus apuntes
arrow_forwardAsignaturas de LA COSTERA - Laboratorio Clínico y Biomédico
Asignatura
arrow_downwardÚltimas publicaciones de LA COSTERA - Laboratorio Clínico y Biomédico
otros
-
INGLÉS LIBROS
English File, 4 edición, pre-intermediate.Libro y workbook, desde tema 1 al 12. También el pocket Book
ejercicios
-
Activitats
He publicado nuevos ejercicios de Técnicas de análisis hematológico: Activitats
ejercicios
-
Actividades BQ
He publicado nuevos ejercicios de Análisis bioquímico: Actividades BQ
apuntes
-
Apuntes_
He publicado nuevos apuntes de Análisis bioquímico: Apuntes_
practicas
-
PRÀCTIQUES IMMUNO
He publicado nuevos practicas de Técnicas de inmunodiagnóstico: PRÀCTIQUES IMMUNO
practicas
-
PRÀCTIQUES MICRO
He publicado nuevos practicas de Microbiología clínica: PRÀCTIQUES MICRO
He publicado nuevos practicas de Análisis bioquímico: LIBRETA-DE-PRACTICAS.pdf
practicas
-
PRÀCTIQUES
He publicado nuevos practicas de Técnicas de análisis hematológico: PRÀCTIQUES
He publicado nuevos ejercicios de Análisis bioquímico: BQ_t1_actv-clase.pdf
apuntes
-
MICRO
He publicado nuevos apuntes de Microbiología clínica: MICRO
apuntes
-
BQ
He publicado nuevos apuntes de Análisis bioquímico: BQ
He publicado nuevos ejercicios de Técnicas generales de laboratorio: ACTIVITAT-2.pdf
He publicado nuevos apuntes de Técnicas generales de laboratorio: Activitats-6-part-2.pdf
He publicado nuevos ejercicios de Técnicas generales de laboratorio: ACTIVITATS-UNITAT-3.pdf
He publicado nuevos apuntes de Biología molecular y citogenética: Tabla-variantes-PCR-3.pdf
He publicado nuevos ejercicios de Fisiopatología general: FG-Actividad-1.pdf
He publicado nuevos ejercicios de Técnicas generales de laboratorio: EXERCICIS-TGL-UNITAT-1.pdf
apuntes
-
Biologia molecular
He publicado nuevos apuntes de Biología molecular y citogenética: Biologia molecular